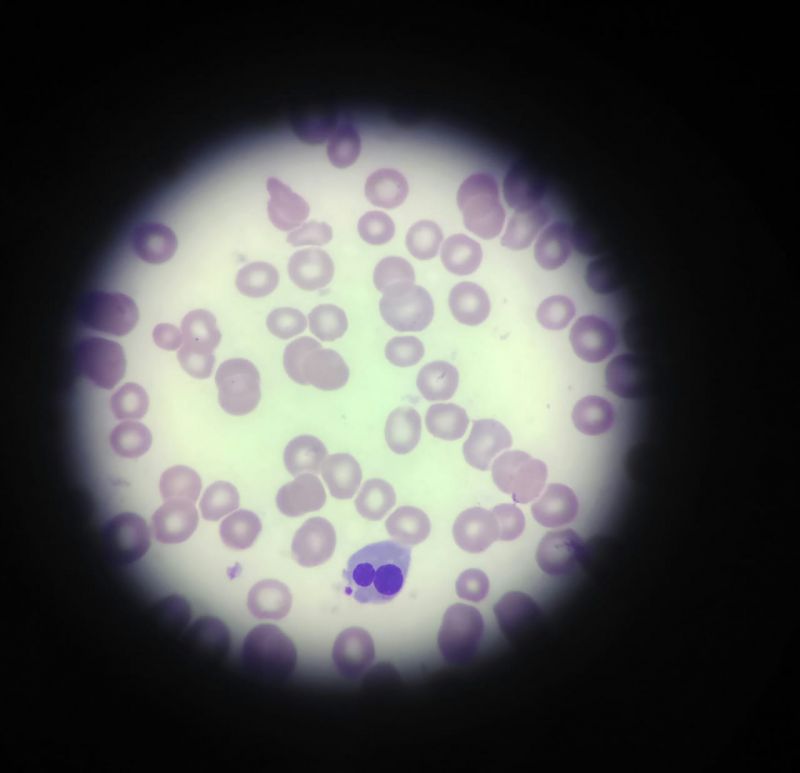

Tricoleucemia e seus achados
#Leucemia #Hematoscopia #Sindromes #HemoClass Leucemias
jpeg.jpg)
O relato de um laboratório do interior do estado do Paraná traz o seguinte:
Paciente 72 anos, masculino
Hemograma:
Eri: 2,21 / Hb: 7,6 / VG: 23,9 / VCM: 108,4 / HCM: 34,6 / CHCM: 31,9 / RDW: 21,1
Leucócitos: 3.200
Dif. Aparelho:
Linfo: 61,8 / Mono: 23,9 / Granulócitos: 14,3
Plaquetas: 22.000
A pancitopenia é observada no hemograma.
Diferencial manual:
Bt 2 / Seg 30 / Eosi 1 / Baso 0 / Linf 62 / Mono 4 / Reat 1
Ao se analisar a lâmina percebe-se vários linfócitos, com citoplasma com aspecto de franjas, que foram descritos como células linfoides variantes, com tamanho médio a grande, núcleo com cromatina densa, citoplasma levemente basofílico com franjas/projeções citoplasmáticas, sugestivo de tricoleucócitos.
A tricoleucemia é uma doença linfoproliferativa crônica de linfócitos B, e está relacionada com a exposição à radiação, benzeno, pesticidas e herbicidas, com incidência maior é em homens com idade entre 50 à 55 anos. Antigamente era conhecida como reticuloendoteliose leucêmica.
Clinicamente se observa sintomas relacionados com anemia, trombocitopenia e leucopenia, podendo ser cansaço, fadiga, fraqueza, além de sangramentos do tipo púrpura (petéquias, equimoses, epistaxe e gengivorragia), além de infecções de recorrência.
A forma pancitopênica prevalece, com 85% dos casos, mas ainda é possível se ter a forma leucêmica (15%), aonde se observa uma leucocitose com anemia e trombocitopenia. Ambas apresentam células cabeludas na extensão.
Nestas situações o acúmulo celular acontece pelo aumento da sobrevida das células e não pela proliferação como em leucemias agudas.
As células cabeludas, ou tricoleucócitos, são maiores que os linfócitos normais, com o citoplasma fracamente basófilo exibindo projeções citoplasmáticas. Em alguns casos ainda se observa granulações citoplasmáticas. O núcleo é excêntrico, arredondado ou oval. Uma prova confirmatória para essa situação é a coloração da Fosfatase Ácida Tartarato Resistente (FATR), que fica positiva em casos de tricoleucemia.
Os critérios de diagnóstico da TL são:
Paciente 72 anos, masculino
Hemograma:
Eri: 2,21 / Hb: 7,6 / VG: 23,9 / VCM: 108,4 / HCM: 34,6 / CHCM: 31,9 / RDW: 21,1
Leucócitos: 3.200
Dif. Aparelho:
Linfo: 61,8 / Mono: 23,9 / Granulócitos: 14,3
Plaquetas: 22.000
A pancitopenia é observada no hemograma.
Diferencial manual:
Bt 2 / Seg 30 / Eosi 1 / Baso 0 / Linf 62 / Mono 4 / Reat 1
Ao se analisar a lâmina percebe-se vários linfócitos, com citoplasma com aspecto de franjas, que foram descritos como células linfoides variantes, com tamanho médio a grande, núcleo com cromatina densa, citoplasma levemente basofílico com franjas/projeções citoplasmáticas, sugestivo de tricoleucócitos.
A tricoleucemia é uma doença linfoproliferativa crônica de linfócitos B, e está relacionada com a exposição à radiação, benzeno, pesticidas e herbicidas, com incidência maior é em homens com idade entre 50 à 55 anos. Antigamente era conhecida como reticuloendoteliose leucêmica.
Clinicamente se observa sintomas relacionados com anemia, trombocitopenia e leucopenia, podendo ser cansaço, fadiga, fraqueza, além de sangramentos do tipo púrpura (petéquias, equimoses, epistaxe e gengivorragia), além de infecções de recorrência.
A forma pancitopênica prevalece, com 85% dos casos, mas ainda é possível se ter a forma leucêmica (15%), aonde se observa uma leucocitose com anemia e trombocitopenia. Ambas apresentam células cabeludas na extensão.
Nestas situações o acúmulo celular acontece pelo aumento da sobrevida das células e não pela proliferação como em leucemias agudas.
As células cabeludas, ou tricoleucócitos, são maiores que os linfócitos normais, com o citoplasma fracamente basófilo exibindo projeções citoplasmáticas. Em alguns casos ainda se observa granulações citoplasmáticas. O núcleo é excêntrico, arredondado ou oval. Uma prova confirmatória para essa situação é a coloração da Fosfatase Ácida Tartarato Resistente (FATR), que fica positiva em casos de tricoleucemia.
Os critérios de diagnóstico da TL são:
- presença de pancitopenia,
- presença de hairy cells no sangue periférico,
- esplenomegalia (ocorre em 90% dos pacientes)
- infecções de recorrência (devido a pancitopenia).
A prova citoquímica da FATR associada com os critérios acima é essencial para o diagnóstico.
O diagnóstico definitivo acaba acontecendo por biópsia de medula óssea e não por aspirado, uma vez que é comum a fibrose medular em casos de tricoleucemia.
O imunofenótipo do tricoleucócito é o de uma célula B madura: CD19, CD20, CD22 e CD79a, sendo que a expressão de CD22 é forte.
O diagnóstico definitivo acaba acontecendo por biópsia de medula óssea e não por aspirado, uma vez que é comum a fibrose medular em casos de tricoleucemia.
O imunofenótipo do tricoleucócito é o de uma célula B madura: CD19, CD20, CD22 e CD79a, sendo que a expressão de CD22 é forte.
Gostou do nosso conteúdo?
Cadastre-se para receber nossos conteúdos exclusivos.

jpeg.jpg)

jpeg.jpg)
jpeg.jpg)



